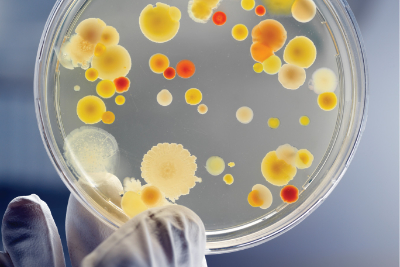

Biochemistry
Biochemistry and Immunoassay divisions are lined with fully-automated, progressive integrated analyzers, wherein diverse tests are conducted from a single specimen without the need of aliquoting...
View More
Clinical Pathology
Clinical Pathology division analyzes blood samples, urine samples, sputum samples, stool samples and other body fluid samples using different diagnostic tools under a microscope...
View More
Cytopathology
The Cytopathology Laboratory diagnoses malignant and premalignant lesions and diseases on the microscopic level. The doctors have vast experience in performing a procedure called fine needle...
View More
Genetics and Molecular
Genetics is a basically a study in heredity, particularly the mechanisms of hereditary transmission, and the variation of inherited characteristics among similar or related organisms...
View More
Haematology
The Hematoglogy division diagnoses several anaemias, leukemia, disorders of hemostatis, hemoglobinopathies and thrombosis. Ours is a full-service laboratory offering variant hemoglobin analysis...
View More
Histopathology
Histopathology is the diagnosis and study of diseases of the tissues, and involves examining tissues and/or cells under a microscope. Histopathologists are responsible for making tissue diagnoses and...
View More
Immunology
Immunology is the study of the immune system and is a very important branch of the medical and biological sciences. The immune system protects us from infection through various lines of defence...
View More
Microbiology
At our NABL-accredited ‘Division of Microbiology & Molecular Testing’, we are dedicated to providing cutting-edge medical microbiology and molecular testing services to support healthcare professionals...
View More